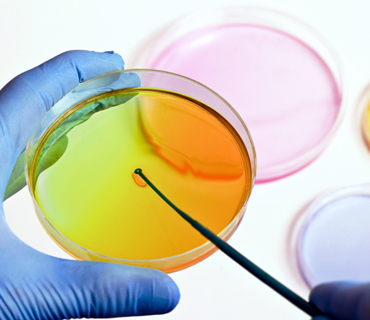
petri_dish petri_dish

Hire our experienced team for your food audit preparation
Food audits have some of the strictest standards out there, and rightfully so. When companies need to get their plants up to Health & Safety compliance levels, they call Industrial Cleaning Specialists.